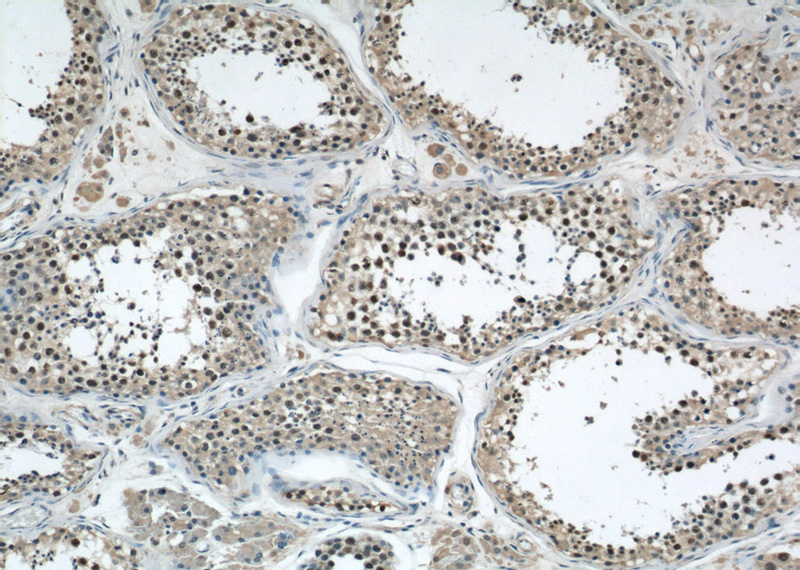
Immunohistochemical of paraffin-embedded human testis using Catalog No:110517(FANCD2 antibody) at dilution of 1:50 (under 10x lens)
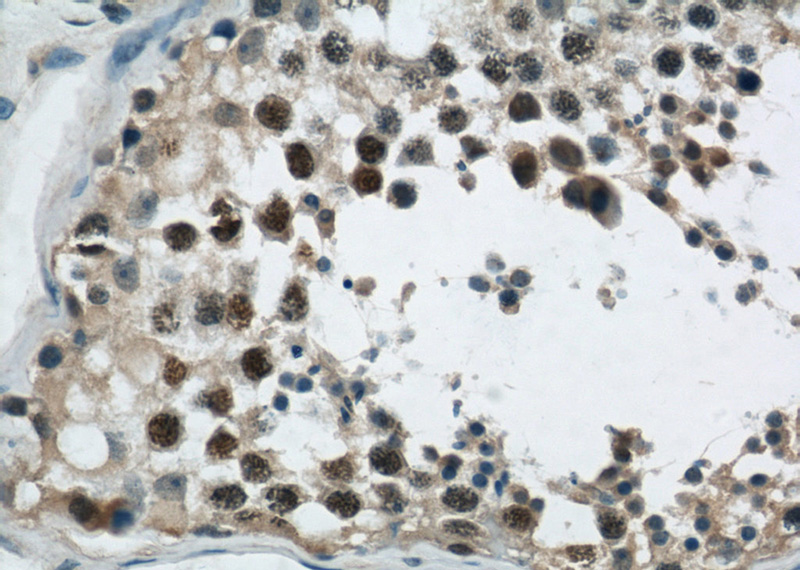
Immunohistochemical of paraffin-embedded human testis using Catalog No:110517(FANCD2 antibody) at dilution of 1:50 (under 40x lens)

-
Product Name
FANCD2 antibody
- Documents
-
Description
FANCD2 Rabbit Polyclonal antibody. Positive IHC detected in human testis tissue. Positive WB detected in HL-60 cells. Positive IP detected in mouse testis tissue. Observed molecular weight by Western-blot: 150-155kd
-
Tested applications
ELISA, WB, IHC, IP
-
Species reactivity
Human, Mouse; other species not tested.
-
Alternative names
DKFZp762A223 antibody; FA D2 antibody; FA4 antibody; FACD antibody; FAD antibody; FAD2 antibody; FANCD antibody; FANCD2 antibody; FLJ23826 antibody; Protein FACD2 antibody
-
Isotype
Rabbit IgG
-
Preparation
This antibody was obtained by immunization of Peptide (Accession Number: NM_033084). Purification method: Antigen affinity purified.
-
Clonality
Polyclonal
-
Formulation
PBS with 0.02% sodium azide and 50% glycerol pH 7.3.
-
Storage instructions
Store at -20℃. DO NOT ALIQUOT
-
Applications
Recommended Dilution:
WB: 1:200-1:1000
IP: 1:200-1:1000
IHC: 1:20-1:200
-
Validations

HL-60 cells were subjected to SDS PAGE followed by western blot with Catalog No:110517(FANCD2 antibody) at dilution of 1:300

IP Result of anti-FANCD2 (IP:Catalog No:110517, 4ug; Detection:Catalog No:110517 1:300) with mouse testis tissue lysate 6000ug.
Immunohistochemical of paraffin-embedded human testis using Catalog No:110517(FANCD2 antibody) at dilution of 1:50 (under 10x lens)
Immunohistochemical of paraffin-embedded human testis using Catalog No:110517(FANCD2 antibody) at dilution of 1:50 (under 40x lens)
-
Background
FANCD2, also named as FACD and FACD2, is required for maintenance of chromosomal stability. FANCD2 promotes accurate and efficient pairing of homologs during meiosis. FANCD2 is involved in the repair of DNA double-strand breaks, both by homologous recombination and single-strand annealing. It may participate in S phase and G2 phase checkpoint activation upon DNA damage. It promotes BRCA2/FANCD1 loading onto damaged chromatin. FANCD2 may also be involved in B-cell immunoglobulin isotype switching. Defects in FANCD2 are a cause of Fanconi anemia (FA) which is a genetically heterogeneous, autosomal recessive disorder characterized by progressive pancytopenia, a diverse assortment of congenital malformations, and a predisposition to the development of malignancies. The antibody recognize both un-phospho and phospho-Ser(330) of FANCD2.
Related Products / Services
Please note: All products are "FOR RESEARCH USE ONLY AND ARE NOT INTENDED FOR DIAGNOSTIC OR THERAPEUTIC USE"
